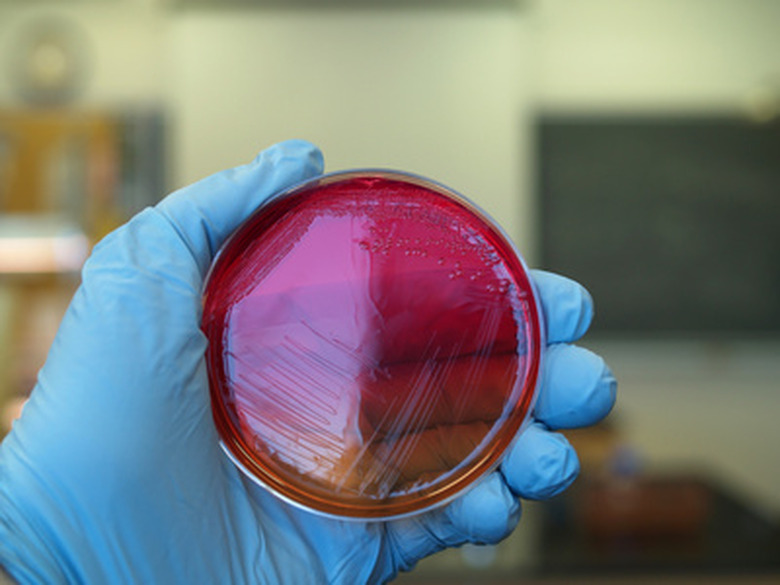
...

How To Test For Bacteria On Kitchen Counters
Things Needed
-
Agar
-
Petri dishes
-
Cotton swabs
Some nasty bugs may lurk on your kitchen counters, in your kitchen drains and even inside your refrigerator. E. Coli and salmonella, two common types of bacteria found in beef and chicken, cause intense gastrointestinal discomfort, and even death if left untreated. Finding out if these unwelcome guests have taken up residence in your kitchen is the first step to being rid of them. Home testing for bacteria is simple and affordable, and doesn't require advanced scientific knowledge.
Step 1
Prepare a small sample of agar in the petri dish as directed on its package. Agar is a gelatinous substance used in cooking that also serves as a growth medium suitable for science experiments. Refrigerate your sample upside down for the specified amount of time.
Step 2
Rub a sterile swab over the areas of your counter most prone to collecting bacteria. Check a variety of different areas, focusing on where you most often handle your food. For example, you can collect samples from the edges of the sink, as well as the back of your spice rack and the bottom of your knife block. Use a light touch, but make full contact with the surface.
Step 3
Rub the swab containing your sample onto the prepared agar and close the petri dish.
Step 4
Place your petri dishes in an out-of-the way spot, out of direct light. It will take three to seven days for growth to appear.
Step 5
Examine your petri dishes as growth begins to appear. While determining the types of fungi and bacteria found must be left to the professionals, you can easily identify bacteria as small white and yellow spots that multiply quickly, and fungi as larger, colorful, furry areas. The more spots, the higher your bacterial count.
Tip
You can find complete testing kits through online science equipment suppliers and home-school suppliers. Look for kits that include all your test components — the agar, petri dishes and sterile swabs.
Use a separate petri dish for each area tested. Or, you can cross-section a dish by using a marker on the bottom and labeling each section.
You can use plastic containers instead of petri dishes, but you must make certain the insides are sterile.
Warning
Wash your hands thoroughly after handling your home-grown cultures.